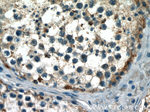
CCDC99 Antibody in Immunohistochemistry (Paraffin) (IHC (P))

Search
Proteintech
CCDC99 Polyclonal Antibody
{{$productOrderCtrl.translations['antibody.pdp.commerceCard.promotion.promotions']}}
{{$productOrderCtrl.translations['antibody.pdp.commerceCard.promotion.viewpromo']}}
{{$productOrderCtrl.translations['antibody.pdp.commerceCard.promotion.promocode']}}: {{promo.promoCode}} {{promo.promoTitle}} {{promo.promoDescription}}. {{$productOrderCtrl.translations['antibody.pdp.commerceCard.promotion.learnmore']}}
产品信息
24689-1-AP
种属反应
宿主/亚型
分类
类型
抗原
偶联物
形式
浓度
规格
纯化类型
保存液
内含物
保存条件
运输条件
产品详细信息
Immunogen sequence: AEVEDRRAA MERQLISMKV KYQSLKKQNV FNREQMQRMK LQIATLLQMK GSQTEFEQQE RLLAMLEQKN GEIKHLLGEI RNLEKFKNLY DSMESKPSVD SGTLEDNTYY TDLLQMKLDN LNKEIESTKG ELSIQRMKAL FESQRALDIE RKLFANERCL QLSESENMKL RAKLDELKLK YEPEETVEVP VLKKRREVLP VDITTAKDAC VNNSALGGEV YRLPPQKEET QSCPNSLEDN NLQLEKSVSI HTPVVSLSPH KNLPVDMQLK KEKKCVKLIG VPADAEALSE RSGNTPNSPR LAAESKLQTE VKEGKETSSK LEKETCKKSH PILYVSSKST PETQCPQQ (259-605 aa encoded by BC012568)
靶标信息
The galectins are a family of beta-galactoside-binding proteins implicated in modulating cell-cell and cell-matrix interactions. Differential and in situ hybridizations indicate that this lectin is specifically expressed in keratinocytes. It is expressed at all stages of epidermal differentiation (i.e., in basal and suprabasal layers). The protein was found mainly in stratified squamous epithelium. It is moderately repressed by retinoic acid. The antigen localized to basal keratinocytes, although it was also found at lower levels in the suprabasal layers, where it concentrated to areas of cell-to-cell contact. The cellular localization and its striking down-regulation in cultured keratinocytes imply a role in cell-cell and/or cell-matrix interactions necessary for normal growth control.
仅用于科研。不用于诊断过程。未经明确授权不得转售。
生物信息学
蛋白别名: ARG1; Arsenite-related gene 1 protein; Coiled-coil domain-containing protein 99; hSpindly; Protein Spindly; Rhabdomyosarcoma antigen MU-RMS-40.4A; rrhabdomyosarcoma antigen protein MU-RMS-40.4A; Spindle apparatus coiled-coil domain-containing protein 1; unnamed protein product
基因别名: CCDC99; SPDL1
UniProt ID: (Human) Q96EA4
Entrez Gene ID: (Human) 54908